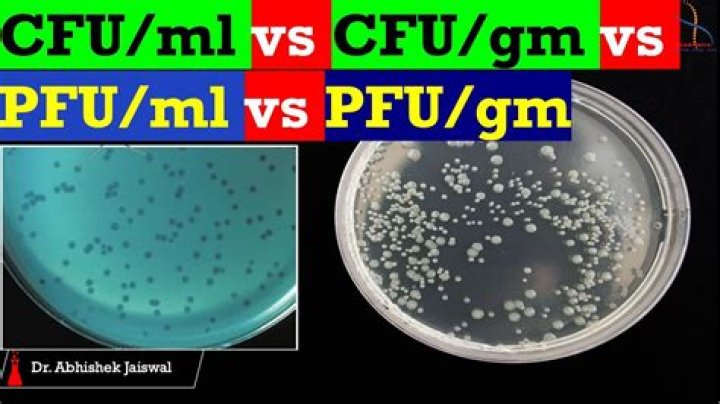

What does PFU ml indicate
If we take the titer of a virus preparation (in plaque forming-units per milliliter) and divide it by into the number of virus particles in the sample, we obtain a number known as the particle-to-PFU ratio. It is a measure of the fraction of virus particles in a given sample that can complete an infectious cycle.
How do you calculate PFU per ml?
Then use the formula: (total PFU needed) / (PFU/ml) = total ml of virus needed to reach your desired dose. For example: You have a virus with a titer of 1.3×1011 PFU/ml and a well that contains 1.8×106 cells.
What does a high PFU mean?
A high particle-to-pfu ratio is sometimes caused by the presence of noninfectious particles with genomes that harbor lethal mutations or that have been damaged during growth or purification.
What unit is PFU?
A plaque-forming unit (PFU) is a measure used in virology to describe the number of virus particles capable of forming plaques per unit volume.What is PFU in virus?
Plaque forming units (PFU) are a measure of the quantity of viruses that are capable of lysing host cells and forming a plaque.
What is particle to PFU ratio?
The term particle/PFU ratio refers to the number of viral particles required to form one plaque in a plaque assay. It is a measure of the efficiency by which a virus infects cultured cells.
Is PFU the same as CFU?
Plaque-forming units (PFUs) are equivalent in concept to colony-forming units (CFUs) when plating bacteria, that is, where a single bacterium, bacterial arrangement, or clump of bacteria all can give rise to only a single colony upon plating.
What does CFU mean in microbiology?
Colony-Forming Unit. A CFU is defined as a single, viable propagule that produces a single colony (a population of the cells visible to the naked eye) on an appropriate semisolid growth medium.How do you convert moi to PFU?
MOI is related to pfu by the following formula: Multiplicity of infection (moi) = Plaque forming units (pfu) of virus used for infection / number of cells. For example, if 2×106 cells is infected by 50 ml of virus with a titer of 108 pfu/ml.
How many viruses are needed to form a plaque?One virus is enough to form a plaque. So for one-hit kinetics, the number of plaques is directly proportional to the first power of the concentration of the virus inoculated.
Article first time published onWhat is CFU mL?
colony-forming unit (CFU or cfu) is a measure of viable bacterial or fungal cells. … For convenience the results are given as CFU/mL (colony-forming units per milliliter) for liquids, and CFU/g (colony-forming units per gram) for solids.
What does a colony-forming unit CFU represent?
A colony-forming unit (CFU, cfu, Cfu) is a unit used in microbiology. It estimates the number of bacteria or fungal cells in a sample which are viable, able to multiply via binary fission under the controlled conditions. … Expressing results as colony-forming units reflects this uncertainty.
How do you calculate CFUS?
To find out the number of CFU/ ml in the original sample, the number of colony forming units on the countable plate is multiplied by 1/FDF. This takes into account all of the dilution of the original sample. For the example above, the countable plate had 200 colonies, so there were 200 CFU, and the FDF was 1/4000.
What is a full plate titer?
The full plate titer allows for easier and more accurate plaque counting, but also requires more plates and time than the “quick and dirty” method. Either method can lead to successful results. The best titer calculation is always obtained from a single plate with 20 – 200 plaques.
How is phage therapy done?
Phages work against both treatable and antibiotic-resistant bacteria. They may be used alone or with antibiotics and other drugs. Phages multiply and increase in number by themselves during treatment (only one dose may be needed). They only slightly disturb normal “good” bacteria in the body.
How do you calculate PFU from TCID50?
The titer as measured by TCID50 is 0.7 Log higher than the titer by standard plaque assay. To transform TCID50/ml into PFU/ml: T = 1 X 108.
What does MOI 1 mean?
The multiplicity of infection or MOI represents the ratio of the numbers of virus particles to the numbers of the host cells in a given infection medium. A value of MOI = 1 implies that on an average there is a single host cell for a single phage particle.
How do you dilute a viral stock?
Prepare serial dilutions of your viral stock. Dilutions of 10-4 & 10-5 are usually suitable. Add 100μl of the 10-4 dilution to a well, and 100μl of the 10-5 dilution to another well. For increased accuracy, 2 wells should be infected with each duplicate and plaque counts averaged at the end.
What does Billion mean in probiotics?
What is a probiotic billion count? The billions count of a probiotic supplement refers to the total number of live bacteria that are contained within each capsule or serving. So, for example, our supplement Every Day provides 5 billion live microorganisms per capsule, and this number is guaranteed until end of expiry.
How many CFU is too much?
There’s no general rule to follow. Most doses range from 1 to 10 billion CFUs that you take once or twice a day. If you don’t get enough CFUs, you might not get the results you want. But more isn’t always better.
Is CFU mL the same as CFU g?
cfu stands for colony-forming unit. This means that cfu/g is colony-forming unit per gram and cfu/ml is colony-forming unit per millilitre. … They give you the results of the number of colony-forming units, for the number of grams or millilitres of test material that they put on the petri dish.
How do you plaque purify a virus?
Virus stocks prepared from a single plaque are called plaque purified virus stocks. To prepare such virus stocks, the tip of a small pipette is inserted into the agar overlay above the plaque. The plug of agar is removed and placed in buffer.
How are viruses counted?
The titer of a virus stock can be calculated in plaque-forming units (PFU) per milliliter. To determine the virus titer, the plaques are counted. To minimize error, only plates containing between 10 and 100 plaques are counted, depending on the size of the cell culture plate that is used.
Is more probiotics better?
The average probiotic supplement has between 1 billion and 10 billion CFUs per serving. In recent years, some companies have focused on extremely high CFU counts, claiming that higher CFUs means better results. But don’t be fooled—higher CFUs doesn’t necessarily mean it’s a better product.
Why is CFU important?
CFU counts can be useful in helping determine the number of viable probiotics in a supplement, but these numbers shouldn’t be the center of attention. The most important factor in any probiotic supplement is how effectively it delivers a well-researched, bioactive strain to the gut.
Why use CFU mL instead of cells?
Unlike in direct microscopic counts where all cells, dead and living, are counted, CFU measures viable cells. By convenience the results are given as CFU/mL, colony-forming units per milliliter. The theory behind the technique of CFU establish that a single bacterium can grow and become a colony, via binary fission.
What is the best CFU count for probiotics?
Researchers suggest that probiotics must contain at least 106 (1,000,000) viable CFUs per gram to be able to survive digestion and exert positive effects in the body (4). It’s suggested that the minimum recommended effective dose per day is 108–109 cells or 100,000,000–1 billion cells ( 5 ).
What is colony count in medical terms?
A measurement of the growth of bacteria in a urine sample that has been cultured for 24 to 48 hours.
How do you convert CFU ml to colonies?
Calculate the number of bacteria (CFU) per milliliter or gram of sample by dividing the number of colonies by the dilution factor The number of colonies per ml reported should reflect the precision of the method and should not include more than two significant figures.



